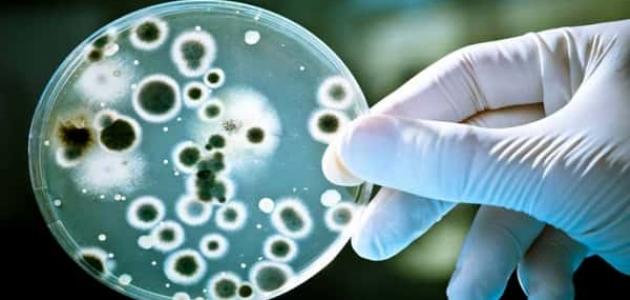

كانديدا المهبل
تعد الكانديدا أحد أنواع الخمائر، وهي نوع من الفطريات التي تتواجد بصورة طبيعية في بعض المناطق داخل جسم الإنسان مثل الفم والحلق والأمعاء والمهبل، كما وتتواجد خارجه على الجلد من دون التّسبب بأيّ مشاكل للجسم، ولكن عند حدوث تغيرات معينة في بيئة المهبل بسبب الهرمونات أو الأدوية أو لمناعة، قد تؤدي هذه التّغيرات إلى تشجيع نمو وتكاثر الكانديدا، فتصبح الكانديا ضارية وقادرة على التّسبب بالتهابات في المهبل، ويطلق على التهاب المهبل بسبب الكانديدا المهبلية داء المبيضات، كما يمكن أن تسبب الكانديدا التهابًا بالفرج، وتتعدد أسباب كانديدا المهبل عند السّيدات، إلا أنه مرض شائع ويمكن علاجه بسهولة.
أعراض كانديدا المهبل
كانديدا المهبل من الفطريات التي تسبب تهيجًا وحكة شديدة في المهبل وفي الفرج -المنطقة المحيطة بفتحة المهبل-، كما أنها تسبب إفرازات مهبلية مميزة، وهي شائعة جدًا حيث تصيب ثلاثة من أصل أربعة نساء خلال وقت معين في حياتهم، وتعد أعراض كانديدا المهبل كالآتي:
- حكة وتهيج في المهبل والفرج.
- إحساس بالحرقة، خصوصًا أثناء الجماع أو أثناء التّبول.
- إحمرار وتورم الفرج.
- ألم في المهبل.
- وجود طفح مهبلي.
- إفرازات مهبلية بيضاء وسميكة، لا رائحة لها، تشبه الجبنة.
- إفرازات مهبلية تشبه الماء.
أسباب كانديدا المهبل
يمكن أن تكون كانديا المهبل مرضًا مؤقتًا أو مزمنًا أو متكررًا بشكل مستمر أو دائمًا، وتصيب الكانديدا المهبل والفرج وما حولهما، ويتسبب نوع الكانديدا ألبيكانز بما يقارب 85%-90% من حالات كانديدا المهبل، والباقي تسببه أنواع أخرى من الكانديدا، وتعد أسباب كانديدا المهبل كما يأتي:
ضعف المناعة
إنّ الإصابة بالأمراض التي تضعف المناعة زمة نقص المناعة المكتسبة أو الأدوية التي تقلّل من المناعة كالكورتيزون، تجعل الجسم أكثر عرضة للإصابة بالالتهابات الفطرية، وبالتّالي يعدّ ضعف المناعة أحد أسباب كانديدا المهبل، وقد أظهرت دراسة أجريت عام 2014 على الفئران أن الاستجابة المناعية الذّاتية في الجسم لها دور في حماية الجسم من كانديدا المهبل التي تعتبر كائنات انتهازية، أيّ أنها تصبح ضارية عند إنخفاض مناعة الجسم.
الحمل
يؤثر الحمل على بيئة المهبل وعلى الإفرازات المهبلية، وبالتّالي يمكن أن يزيد من نمو وتكاثر الكانديدا في المهبل، وفي الحقيقة فإنّ الحمل من أكثر أسباب كانديدا المهبل شيوعًا، وقد بينت الدّراسات أن ثلث السّيدات الحوامل معرضات لكانديدا المهبل في أيّ لحظة، ويعزى السبب في ذلك إلى أنّ نسبة الهرمونات التّناسلية مرتفعة جدًا عن الحوامل، كما أن ارتفاع تركيز كوجين في المهبل أثناء الحمل يوفر كمية كافية من الكاربون لفطريات الكانديدا حتى تنمو وتتكاثر.
كما أن درجة حموضة المهبل عند الحامل تثبط نمو البكتيريا النّافعة التي تقلل من نمو وتكاثر خمائر الكانديدا، وعلى الرّغم من أن الكانديدا بخلايا المهبل تنمو بشكل أفضل عند درجة حموضة -أيّ الهيدروجيني- تتراوح بين 6-7، إلا أنّ باقي مراحل تكاثر الكانديدا تتم بشكل أفضل عند درجة حموضة أقل من 5.السكري
وجدت دراسة أجراها باحثون عام 2013 على النّساء والأطفال المصابين بمرض السّكري من النّوع الأول أنّ هناك علاقة كبيرة بين ارتفاع السّكر بالدّم وزيادة احتمالية حدوث كانديدا المهبل، ووجدت دراسة أخرى أجريت عام 2014 أنّ النّساء المصابات بمرض السّكري من النوع الثّاني معرّضين أكثر للإصابة بكانديدا المهبل، فعندما يزيد تركيز السّكر في منطقة المهبل بسبب مرض السّكري الذي يؤدي إلى ارتفاع السّكر، تصبح بيئة المهبل مناسبة أكثر لنمو الكانديدا التي تتغذى على السّكر، فتنمو بشكلٍ كبير وتسبّب التهابات بالمهبل عند النساء المصابات بالسّكري، لذلك يجب على النّساء المصابات بمرض السّكري الحفاظ على نسبة السّكر بالدّم ضمن المستويات الطّبيعية لتقليل احتمالية الإصابة بالكانديدا.
الأدوية
تسبب الأدوية العديد من الأعراض الجانبية المزعجة بحسب تأثيرها على جسم الإنسان، وقد تكون بعض الأدوية أحد أسباب كانديدا المهبل، ولذلك عند استخدام أيّ من الأدوية الآتي ذكرها يجب مراجعة الطبيب عند ظهور أي من أعراض كانديدا المهبل، وتعد الأدوية التي يمكن أن تسبب كانديدا المهبل كالآتي:
- حبوب منع الحمل: تسبب حبوب منع الحمل كانديدا المهبل بسبب احتوائها على نسبة عالية من الإستروجين، الذي يزيد بدوره احتمالية الإصابة بكانديدا المهبل.
- المضادات الحيوية: تعد دات الحيوية فعّالة جدًا في قتل البكتيريا المسبّبة للأمراض، ولكن عند استخدام المضاد الحيوي فإنّه يقوم أيضًا بقتل يريا النّافعة الموجودة بالجسم، مما يعطي فرصة وبيئة مناسبة أكثر لنمو الفطريات وكانديدا المهبل.
- مضادات الالتهاب الستيرويدية: تعمل مضادات الالتهاب الستيرويدية على علاج العديد من الأمراض من خلال خفض مناعة الجسم، مما يتيح الفرصة أمام الكانديدا لتسبب التهابات مهبلية.
- العلاج الكيماوي: يعمل ج الكيماوي على خفض مناعة الجسم بشكلٍ كبير، فيصبح الجسم غير قادر على محاربة الكانديدا مما يتيح لها الفرصة لتسبب التهابات مهبلية.
زيادة هرمون الإستروجين
تزيد احتمالية الإصابة بكانديدا المهبل عند ارتفاع الإستروجين بالجسم، ولذلك يلاحظ زيادة الإصابة بكانديدا المهبل في فترة الحمل وفي مرحلة الطّور الأصفري من الدّورة الشهرية لأن هرمون الإستروجين يكون مرتفعًا في هذه الحالات، ولكن إلى الآن لم يتم تفسير الآلية التي يسبّب فيها ارتفاع الإستروجين كانديدا المهبل.
علاج كانديدا المهبل
يمكن علاج كانديدا المهبل باستخدام مضادات الفطريات التي تصرف بدون وصفة طبية، وتكون على شكل كريمات أو مراهم أو تحاميل مثل المايكونازول والكلوترايمازول، وتكون مدة العلاج من يوم إلى 7 أيام بحسب الدّواء المستخدم، كما ويوجد أدوية تصرف بوصف طبية لعلاج كانديدا المهبل مثل كبسولة الفلوكونازول التي تأخذ بجرعة واحدة فقط، وتعد الأدوية الموضعية أيّ التي على شكل كريم أو تحاميل أكثر أمانًا للحامل، وإذا كانت السّيدة مصابة بالسّكري أو بأمراض تضعف المناعة فقد تعاني من تكرار حدوث الكانديدا المهبلية، وفي حالة تكرارها 4 مرات في السّنة أو أكثر قد يوصي الطّبيب بتناول حبة فلوكونازول واحدة أسبوعيًا لمدة 6 شهور.